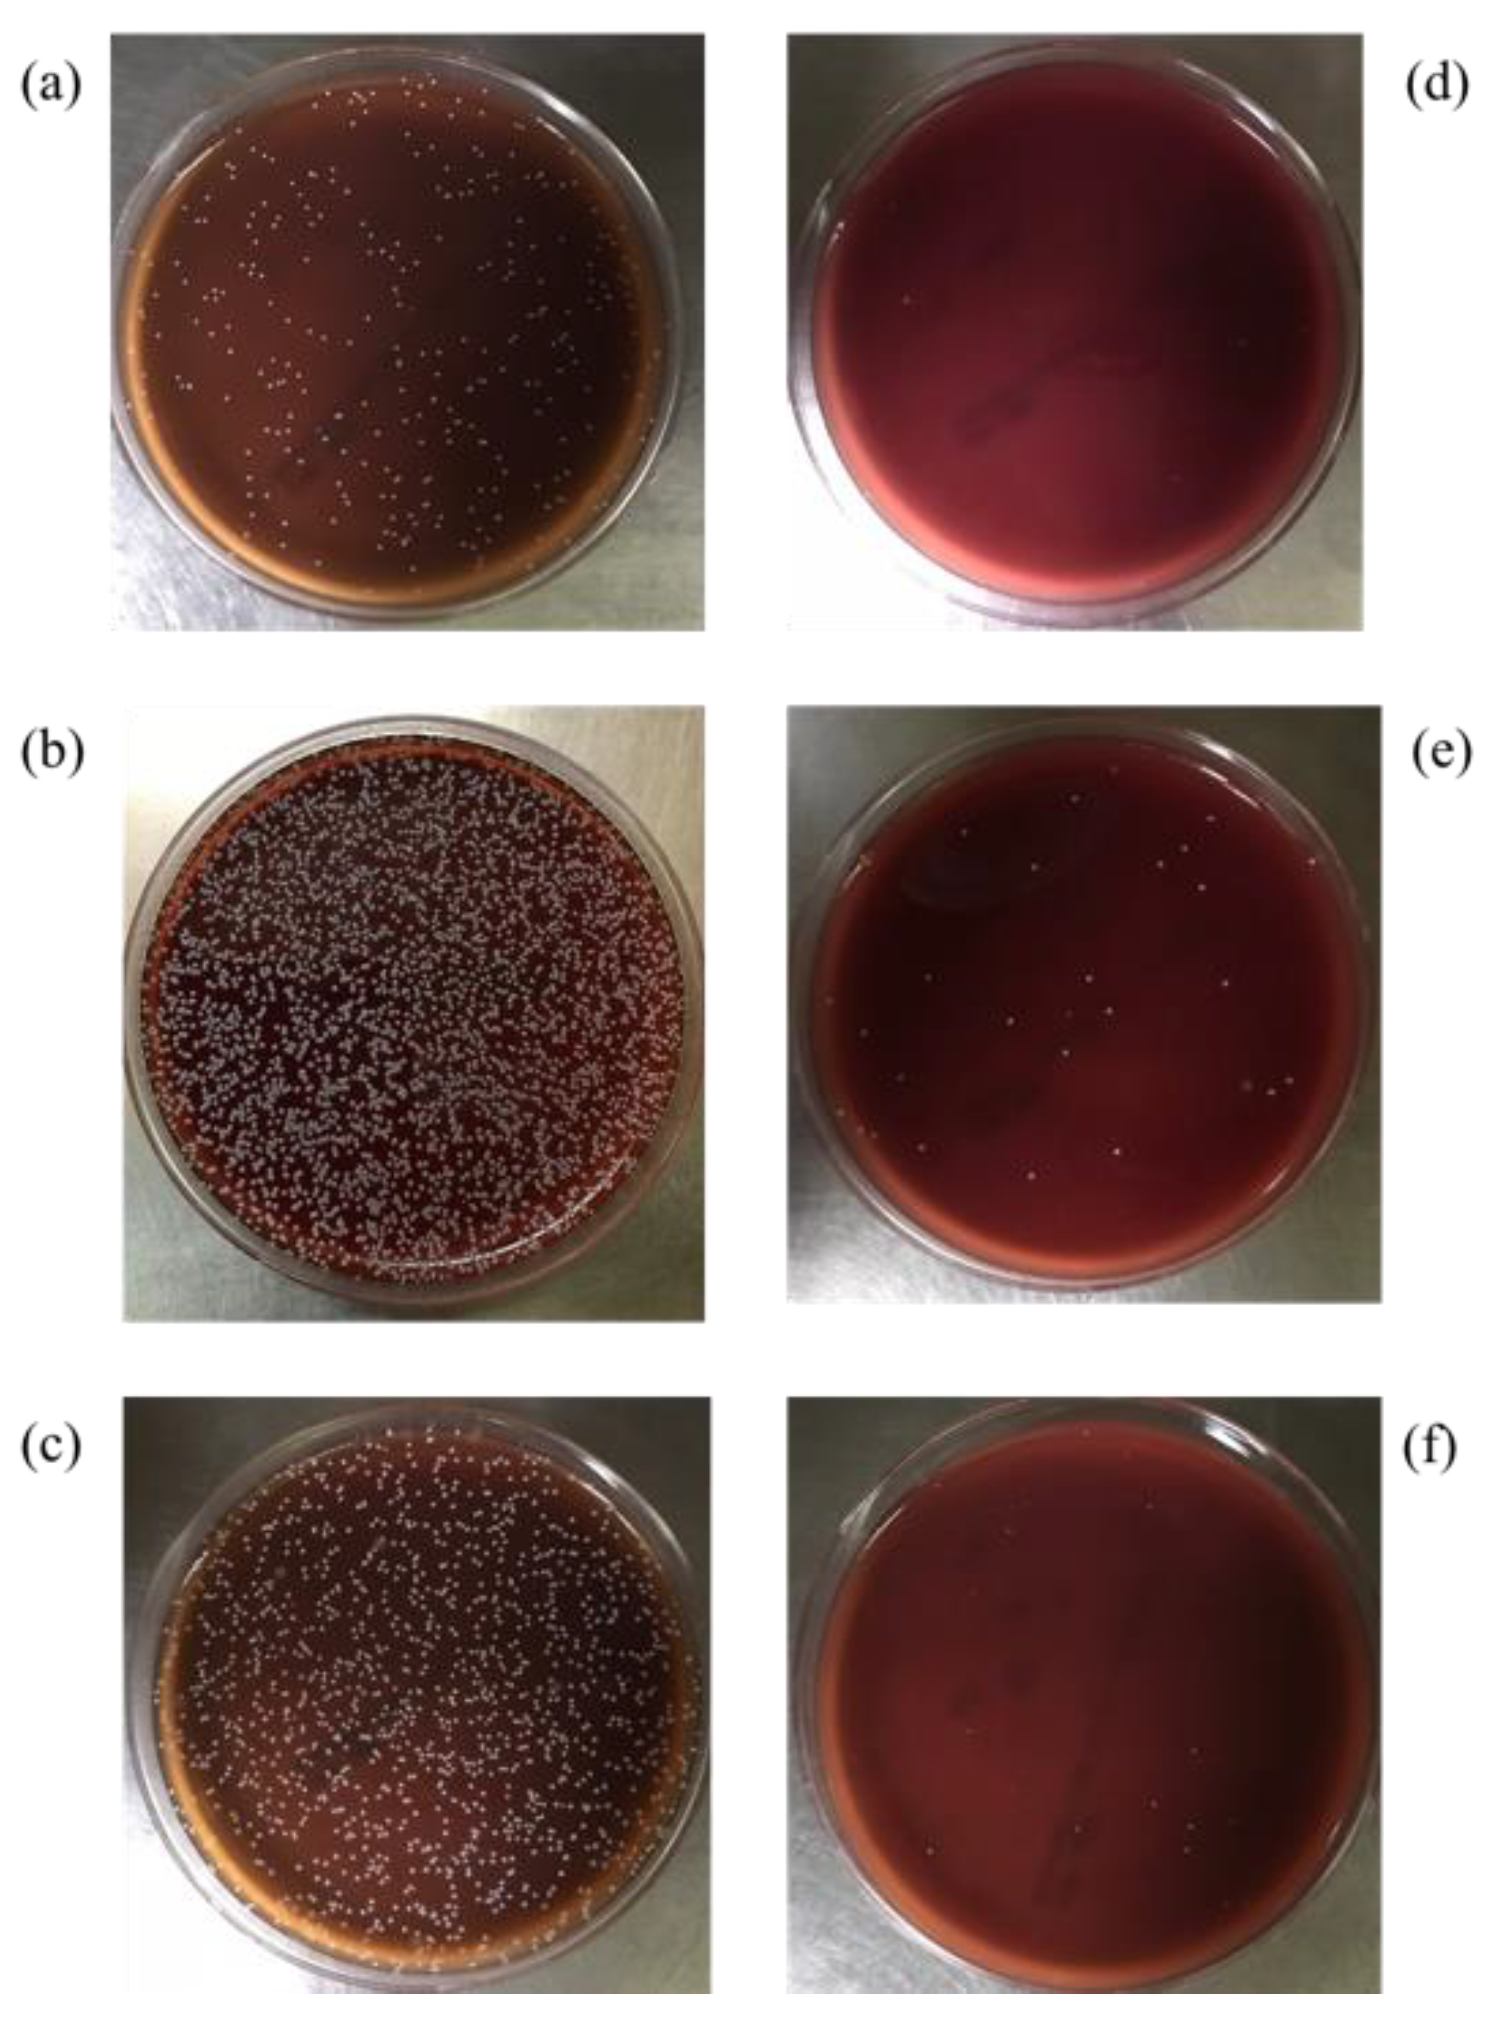
Polymers 13 03593 g009 550

Preparation of Biomimetic 3D Gastric Model with Photo-Curing Resin and Evaluation the Growth of Helicobacter pylori
Abstract
:1. Introduction
2. Materials and Methods
2.1. Preparation of Photo-Curing Resin with IR
2.2. Viscosity Measurements of the Photo-Curing Resin
2.3. Stretch Properties of the Photo-Curing Resin
2.4. Fourier Transform Infrared Spectrometer Analysis
2.5. Resin Printing Formability
2.6. Surface Modification of the Photo-Curing Resin
2.7. WCA
2.8. In Vitro Test of H. pylori
2.9. Culturing H. pylori Growth under Different Conditions
2.10. Evaluation of the H. pylori Adhesion Effect
2.11. Evaluation of the Antibacterial Effect of the 2D and 3D Models
2.12. Statistical Analysis
3. Results and Discussion
3.1. Effect of Diluent Monomers and IR on the Resin Rheology
3.2. Analysis of the Mechanical Properties of the Materials
3.3. Resin Printability
3.4. Conversion Rates of the Photo-Curing Resins
3.5. Resin-Surface Modification
3.6. In Vitro Test of Helicobacter pylori
3.6.1. Comparison of H. pylori Growth before and after Plasma Treatment
3.6.2. Culturing H. pylori in a pH = 2 Environment
3.6.3. Comparison of H. pylori Adhesion Effect
3.7. Evaluation of Antibacterial Effect in the 2D and 3D Models
4. Conclusions
Author Contributions
Funding
Institutional Review Board Statement
Informed Consent Statement
Data Availability Statement
Acknowledgments
Conflicts of Interest
References
- Radenkovic, D.; Solouk, A.; Seifalian, A. Personalized development of human organs using 3D printing technology. Med. Hypotheses 2016, 87, 30–33. [Google Scholar] [CrossRef] [Green Version]
- Ren, Y.; Yang, X.; Ma, Z.; Sun, X.; Zhang, Y.; Li, W.; Yang, H.; Qiang, L.; Yang, Z.; Liu, Y.; et al. Developments and Opportunities for 3D Bioprinted Organoids. Int. J. Bioprint. 2021, 7, 364. [Google Scholar] [PubMed]
- Turner, B.N.; Gold, S.A. A review of melt extrusion additive manufacturing processes: II. Materials, dimensional accuracy, and surface roughness. Rapid Prototyp. J. 2015, 21, 250–261. [Google Scholar] [CrossRef]
- Temple, J.P.; Hutton, D.L.; Hung, B.P.; Huri, P.Y.; Cook, C.A.; Kondragunta, R.; Jia, X.; Grayson, W.L. Engineering anatomically shaped vascularized bone grafts with hASCs and 3D-printed PCL scaffolds. J. Biomed. Mater. Res. Part. A 2014, 102, 4317–4325. [Google Scholar] [CrossRef] [PubMed]
- Peltola, S.M.; Melchels, F.; Grijpma, D.W.; Kellomäki, M. A review of rapid prototyping techniques for tissue engineering purposes. Ann. Med. 2008, 40, 268–280. [Google Scholar] [CrossRef] [PubMed] [Green Version]
- Matesanz, R.; Mahillo, B.; Alvarez, M.; Carmona, M. Global Observatory and Database on Donation and Transplantation: World Overview on Transplantation Activities. Transplant. Proc. 2009, 41, 2297–2301. [Google Scholar] [CrossRef]
- Tao, J.; Zhang, J.; Du, T.; Xu, X.; Deng, X.; Chen, S.; Liu, J.; Chen, Y.; Liu, X.; Xiong, M.; et al. Rapid 3D printing of functional nanoparticle-enhanced conduits for effective nerve repair. Acta Biomater. 2019, 90, 49–59. [Google Scholar] [CrossRef]
- Quan, H.; Zhang, T.; Xu, H.; Luo, S.; Nie, J.; Zhu, X. Photo-curing 3D printing technique and its challenges. Bioact. Mater. 2020, 5, 110–115. [Google Scholar] [CrossRef]
- Chen, F.; Li, R.; Sun, J.; Lu, G.; Wang, J.; Wu, B.; Li, J.; Nie, J.; Zhu, X. Photo-curing 3D printing robust elastomers with ultralow viscosity resin. J. Appl. Polym. Sci. 2021, 138, 49965. [Google Scholar] [CrossRef]
- Bae, J.-H.; Won, J.; Lim, W.; Lee, J.; Min, J.; Kim, S.; Kim, J.-H.; Huh, P. Highly Flexible and Photo-Activating Acryl-Polyurethane for 3D Steric Architectures. Polymers 2021, 13, 844. [Google Scholar] [CrossRef]
- Pelletier, V.; Petit, Y.; Brailovski, V.; Denis, R.; Studer, A.S.; Wagnac, E. Printing a 3D Stomach Teaching Tool for Bariatric Sur-gery, Substance ÉTS. Available online: https://espace2.etsmtl.ca/id/eprint/17167.2017.11.15 (accessed on 7 August 2018).
- Rébé, N. Trans-humanism and Medical Progress. Artif. Intell. Robot. Law Policy Ethics 2021, 44–51. [Google Scholar] [CrossRef]
- Lama, S.B.; Maçôas, E.S.; Coda, F.E.; Alemán, C.; Pineda, E.; Ferreira, F.C. Investigation of the mechanical properties and biocompatibility of planar and electrospun alkene-styrene copolymers against P(VDF-TrFE) and porcine skin: Potential use as second skin substrates. J. Mech. Behav. Biomed. Mater. 2021, 119, 104481. [Google Scholar] [CrossRef] [PubMed]
- Kerche-Silva, L.E.; Cavalcante, D.G.; Job, A.E. Natural Rubber Latex Biomaterials in Bone Regenerative Medicine. Biomater. Regen. Med. 2018, 1, 13. [Google Scholar]
- Holden, G. Viscosity of polyisoprene. J. Appl. Polym. Sci. 1965, 9, 2911–2925. [Google Scholar] [CrossRef]
- Kim, D.; Lee, D.G.; Kim, J.C.; Lim, C.S.; Kong, N.S.; Jung, H.W.; Noh, S.M.; Park, Y.I. Effect of molecular weight of polyurethane toughening agent on adhesive strength and rheological characteristics of automotive structural adhesives. Int. J. Adhes. Adhes. 2017, 74, 21–27. [Google Scholar] [CrossRef]
- Hunt, P.A. Why Does a Reduction in Hydrogen Bonding Lead to an Increase in Viscosity for the 1-Butyl-2,3-dimethyl-imidazolium-Based Ionic Liquids? J. Phys. Chem. B 2007, 111, 4844–4853. [Google Scholar] [CrossRef]
- Baboo, M.; Dixit, M.; Sharma, K.; Saxena, N.S. Mechanical and thermal characterization of cis-polyisoprene and trans-polyisoprene blends. Polym. Bull. 2011, 66, 661–672. [Google Scholar] [CrossRef]
- Lim, Y.-J.; Deo, D.; Singh, T.P.; Jones, D.B.; De, S. In situ measurement and modeling of biomechanical response of human cadaveric soft tissues for physics-based surgical simulation. Surg. Endosc. 2008, 23, 1298–1307. [Google Scholar] [CrossRef] [Green Version]
- Paul, D.; Robeson, L. Polymer nanotechnology: Nanocomposites. Polymer 2008, 49, 3187–3204. [Google Scholar] [CrossRef] [Green Version]
- Quitzau, M.; Wolter, M.; Kersten, H. Plasma Treatment of Polyethylene Powder Particles in a Hollow Cathode Glow Discharge. Plasma Process. Polym. 2009, 6, S392–S396. [Google Scholar] [CrossRef]
- Ma, G.-Q.; Liu, B.; Li, C.; Huang, D.; Sheng, J. Plasma modification of polypropylene surfaces and its alloying with styrene in situ. Appl. Surf. Sci. 2012, 258, 2424–2432. [Google Scholar] [CrossRef]
- Yoshiyama, H.; Nakazawa, T. Unique mechanism of Helicobacter pylori for colonizing the gastric mucus. Microbes Infect. 2000, 2, 55–60. [Google Scholar] [CrossRef]
- Chew, Y.; Chung, H.-Y.; Lin, P.-Y.; Wu, D.-C.; Huang, S.-K.; Kao, M.-C. Outer Membrane Vesicle Production by Helicobacter pylori Represents an Approach for the Delivery of Virulence Factors CagA, VacA and UreA into Human Gastric Adenocarcinoma (AGS) Cells. Int. J. Mol. Sci. 2021, 22, 3942. [Google Scholar] [CrossRef] [PubMed]
- Wu, C.; Yan, Y.; Wang, Y.; Sun, P.; Qi, R. Antibacterial epoxy composites with addition of natural Artemisia annua waste. e-Polymers 2020, 20, 262–271. [Google Scholar] [CrossRef]
- Sizemore, C.F.; Quispe, J.D.; Amsler, K.M.; Modzelewski, T.C.; Merrill, J.J.; Stevenson, D.A.; Foster, L.A.; Slee, A.M. Effects of Metronidazole, Tetracycline, and Bismuth-Metronidazole-Tetracycline Triple Therapy in the Helicobacter pylori SS1 Mouse Model after 1 Day of Dosing: Development of an H. pylori Lead Selection Model. Antimicrob. Agents Chemother. 2002, 46, 1435–1440. [Google Scholar] [CrossRef] [PubMed] [Green Version]

| Pristine | Coating mucin | Coating mucin and urea |
| |
|---|---|---|---|---|
| Illustration | ![]() | ![]() | ![]() | ![]() |
| Pristine | Coating mucin | Coating mucin and urea |
| |
| Illustration | ![]() | ![]() | ![]() | ![]() |
Publisher’s Note: MDPI stays neutral with regard to jurisdictional claims in published maps and institutional affiliations. |
© 2021 by the authors. Licensee MDPI, Basel, Switzerland. This article is an open access article distributed under the terms and conditions of the Creative Commons Attribution (CC BY) license (https://creativecommons.org/licenses/by/4.0/).
Share and Cite
Hsu, Y.-T.; Ho, M.-H.; Lee, S.-P.; Kao, C.-Y. Preparation of Biomimetic 3D Gastric Model with Photo-Curing Resin and Evaluation the Growth of Helicobacter pylori. Polymers 2021, 13, 3593. https://doi.org/10.3390/polym13203593
Hsu Y-T, Ho M-H, Lee S-P, Kao C-Y. Preparation of Biomimetic 3D Gastric Model with Photo-Curing Resin and Evaluation the Growth of Helicobacter pylori. Polymers. 2021; 13(20):3593. https://doi.org/10.3390/polym13203593
Chicago/Turabian StyleHsu, Yu-Tung, Ming-Hu Ho, Shiao-Pieng Lee, and Chen-Yu Kao. 2021. "Preparation of Biomimetic 3D Gastric Model with Photo-Curing Resin and Evaluation the Growth of Helicobacter pylori" Polymers 13, no. 20: 3593. https://doi.org/10.3390/polym13203593
APA StyleHsu, Y.-T., Ho, M.-H., Lee, S.-P., & Kao, C.-Y. (2021). Preparation of Biomimetic 3D Gastric Model with Photo-Curing Resin and Evaluation the Growth of Helicobacter pylori. Polymers, 13(20), 3593. https://doi.org/10.3390/polym13203593









